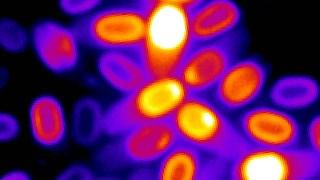

Una sola fuerza puede hoy producir ese entusiasmo, sin cuyo concurso no hay moral posible, y es la que resulta de los Humildes, de los Nadies y las Nadies, de la Justicia Social, Económica yAmbiental y la Paz Total. Sin una corriente de entusiasmo capaz "de vencer todos los obstaculos que oponen la rutina, los prejuicios y la necesidad de goces inmediatos" no hay moral eficaz. Un moralista riguroso, no solamente tiene horror a todo relajamiento de las costumbres, sino que sus exigencias son mayores que las de la moral trivial de las "gentes de bien", que él llama "pequeña moral católica", y que juzga "bastante insípida"; y exige esa tensión del alma que hace realizar las grandes cosas


Leer Más



Las estrellas de neutrones son núcleos supervivientes “compactados” de estrellas masivas que han explotado con un peso superior al del sol. Ahora que sabemos esto, un pedazo de su material superficial pesaría al menos 4 mil millones de toneladas en la Tierra. Por: Ecoo Sfera. Los astrónomos del mundo detectaron una épica colisión entre dos estrellas de neutrones en agosto de 2017 que liberó energía como un supernova, fue la primera detección combinada de ondas gravitacionales y radiación gamma, pero lo que no sabían es que este sería sólo el comienzo, ya que los efectos que vinieron después serían muy interesantes y brindarían información para futuras investigaciones


Leer Más


exige una intervención pública que repare los salarios y estabilice los precios. Por Guillermo
Wierzba. Imagen: Antonio Berni, El mundo prometido a Juanito Laguna. Desigualdad y pobreza, conceptos fundamentales de la economía, son motivo de un debate intenso en la sociedad. Junto a los precios y los salarios, son las categorías que desbordan ampliamente el terreno de lo académico para ocupar lugares centrales en la discusión política y social, de interés popular porque se constituyen en factores cotidianos e inmediatos respecto a las condiciones de vida
LeerMás

Estos escenarios y otros más están en juego, y el tiempo dirá cuál se impondrá. ¿Será factible que los mismos voceros políticos de las fuerzas económicas que han llevado a que Colombia sea uno de los países más desiguales del continente y del mundo procedan como cirujanos del carcomido cuerpo económico, financiero y agrario del país? Por: Carlos Gutiérrez. En los tiempos que corren, quienes habitan el planeta, tal vez consumidos en su mayoría por la confusión o tal vez por conformismo, han dejado a un lado los sueños de revolución


Leer Más

PROPONEN ESCUDO MAGNÉTICO EN MARTE PARA QUE SEA HABITABLE La NASA quiere poner un escudo magnético en Marte para que sea habitable. Por: Ecoo Sfera. La NASA tiene un plan para volver a Marte habitable, en miras de los próximos viajes interplanetarios. Muchos creen que la única manera de que la especie humana subsista a la extinción, es abandonando la Tierra. Pero antes de que esto suceda, primero tendríamos que encontrar un planeta con las condiciones necesarias para habitarlo. Marte está en la mira para este objetivo por ser el más cercano a nosotros, sin embargo, está completamente desolado y la NASA cree que un escudo magnético artificial, lo volvería amigable con los humanos

LeerMás





El Acuerdo deEscazúesun tratado internacional de derechos humanos, de gestión del territorio y del medio ambiente, sujeto al dictamen final de tribunales internacionales. Por Julio César Centeno. Se aplica exclusivamente a países de América Latina y el Caribe. Ninguna otra región del mundo ha suscrito un acuerdo de esta naturaleza. “Es el único acuerdo jurídicamente vinculante derivado de la Conferencia de las Naciones Unidas sobre el Desarrollo Sostenible (Río+20)… es un acuerdo histórico” Antonio Guterres, Secretario General de la Organización de Naciones Unidas
LeerMás


Advertencia de los titulares del FMI y el Banco Mundial. La inflación global, los costos del endeudamiento y las políticas contractivas que aplican los bancos centrales impactan en el ciclo económico mundial. Kristalina Georgieva, directora gerente del FMI. Imagen: EFE. La inflación global se ha tornado un problema persistente y la respuesta ortodoxa de los principales bancos centrales del mundo ha provocado una amenaza al crecimiento económico. Los costos de endeudamiento más altos "realmente están comenzando a afectar" al ciclo, dijo la directora gerente del FMI, Kristalina Georgieva, junto con el presidente del Banco Mundial, David Malpass

Leer Más

Cerebro híbrido: científicos implantan células humanas en ratones y logran influir en su comportamiento. Seis meses después de ser implantados, los grupos de células humanas no solo sobrevivieron, sino que también crecieron hasta ocupar un tercio del hemisferio del cerebro de los roedores. Un grupo de científicos liderado por Sergiu Pasca, profesor de psiquiatría en la Escuela de Medicina de la Universidad de Stanford (EE.UU.), logró crear una especie de cerebro híbrido tras implantar células humanas en ratones de laboratorio. Los resultados de su experimento fueron publicados este 12 de octubre en la revista Nature

LeerMás

de rebelión circulan en el
europeo.

gas ruso, precios bajos de la electricidad! Ilán Semo. Viena, París, Roma, Londres, Berlín…: una ola masiva de demostraciones cimbró en días pasados a las principales capitales de Europa. Un sujeto social, desaparecido desde hace tiempo, reapareció de manera inesperada y multitudinaria con una voz disonante: ¡No a la guerra! Obreros, empleados, técnicos, el magisterio y las grandes centrales sindicales en suma, el mundo del trabajo , salieron a las calles para impugnar la política que, desde el inicio de la pandemia, convirtió

Leer Más


EL NO-
DE ECONOMÍA
El premio Nobel reconoce, también, estos aportes fundamentales para la práctica de los bancos centrales en todo el mundo. Orlando Delgado Selley. El Comité Nobel decidió otorgar este año la distinción a tres economistas que explicaron el papel de los bancos en la economía, en particular durante las crisis financieras, así como la forma de regular los mercados financieros. Los tres premiados son: Douglas W. Diamond y Philip H. Dybvig (por su trabajo Corridas bancarias, seguros para depósitos y liquidez), junto con Ben S. Bernanke (quien escribió: Efectos no monetarios de las crisis financieras en la propagación de la Gran Depresión). Estas explicaciones, publicadas en 1983, siguen siendo
LeerMás

Estamos presenciando un momento de realineación de fuerzas internacionales. La OPEP+ está abiertamente desafiando al gobierno más poderoso del mundo. Lo más interesante de todo es ver cómo Estados Unidos y la Unión Europea..., han quedado relegados a expectadores en este juego. Alonso Romero. La historia reciente de Estados Unidos se resume como la historia de la energía en el siglo XX, el uso de lo que se tiene y la búsqueda de lo que no se tiene. Junto con su aliado en Medio Oriente y de facto líder de la Organización de Países Exportadores de Petróleo (OPEP), Arabia Saudita, Estados Unidos dictó la política energética y monetaria del mundo durante los últimos 40 años... LeerMás



INTESTINO
DOSSIER: 1. Bebé recibe primer trasplante de intestino en el mundo con innovadora técnica. La intervención fue un hito en este tipo de trasplantes y participaron profesionales de hasta sietes especialidades pediátricas. Por: Agencia EFE. Emma, una bebé española de trece meses, es la primera paciente en el mundo en recibir un trasplante multidisciplinar de intestino "en asistolia", una técnica en la que los órganos y tejidos del donante se mantienen con oxigenación extracorpórea una vez certificado su fallecimiento

Leer Más

Una ‘bota’ exoesquelética permite caminar de forma más rápida y eficaz. Ingenieros de la Universidad de Stanford (EE UU) han desarrollado un exoesqueleto de tobillo capaz de adaptarse a cada persona, de tal forma que pueda andar a mayor velocidad y gastar menos energía. El prototipo se ha probado con éxito en condiciones reales, en la calle, y supone un nuevo paso hacia los futuros dispositivos de marcha asistida que podrán utilizar personas con problemas de movilidad. Enrique Sacristán. CEST. Una persona camina asistida por el nuevo exoesqueleto de tobillo portátil. / Stanford University/ Kurt Hickman. Los exoesqueletos que ayudan a mover las piernas, aumentando la velocidad de la marcha

LeerMás





La 'amistad' de Washington ha despertado a más europeos. editorial del Global Times. Por tiempos globales. En los últimos días, los principales países europeos como Alemania y Francia, así como la UE, han hecho declaraciones intrigantes sobre sus relaciones con China y Estados Unidos. El comisario de comercio de la UE, Valdis Dombrovskis, dijo en una conferencia en Berlín el martes que "desvincularse" de China no es una opción para las empresas de la UE. También expresó su "profunda preocupación" sobre la Ley de Reducción de la Inflación de EE. UU., argumentando que la ley discrimina a las industrias automotriz y de energía renovable de la UE. El canciller alemán Olaf Scholz, hablando en la misma conferencia el mismo día, dijo que la desvinculación

LeerMás



"Hemos demostrado que podemos interactuar con las neuronas biológicas vivas de tal manera que se las obliga a modificar su actividad, lo que lleva a algo que se asemeja a la inteligencia". Neuronas humanas aprenden a jugar al Pong en solo cinco minutos. Las aplicaciones de este desarrollo son prometedoras. Tienen “sensaciones” que les permiten interactuar con su entorno, pero no forman un cerebro ni tampoco tienen consciencia. Eduardo Martínez de la Fe. Neuronas del cerebro humano cultivadas en laboratorio pueden aprender a jugar a una especie de tenis de mesa (Pong) no a través de una videoconsola, sino mediante señales eléctricas que emiten los electrodos del plato en el que habitan: les orientan a dar el “raquetazo”… LeerMás


10 MINUTOS Los expertos han conseguido una "combinación récord" de un tiempo de carga más corto y más energía adquirida para Un grupo de científicos de la
Estatal de Pensilvania (EE.UU.) ha desarrollado una batería que permite cargar un vehículo eléctrico en tan solo 10 minutos, según un artículo publicado este miércoles en la revista Nature. Los expertos han conseguido una "combinación récord" de un tiempo de carga más corto y más energía adquirida para un rango de viaje más largo, explicaron los autores en un comunicado
Leer Más

¿Qué quiere decir con que la OTAN "asegurará" que Ucrania gane? Los comentarios del jefe de la OTAN corren el riesgo de llevar la crisis de Ucrania a un abismo en deterioro. La guerra se prolongará y ampliará en el futuro previsible, ya que cada vez es más difícil vislumbrar una solución diplomática y política. Por tiempos globales. El secretario general de la OTAN, Jens Stoltenberg, habla durante una conferencia de prensa antes de la reunión de ministros de Defensa de la alianza en la sede de la OTAN en Bruselas el 15 de marzo de 2022. Foto: AFP. La situación de seguridad en el continente europeo está temblando. Sin embargo, la OTAN

LeerMás

La única forma de evitar que todo empeore es que Estados Unidosentableun diálogo respetuoso con Rusia y China como verdaderos iguales, algo que detesta hacer. Recuerden la crisis de los misiles en Cuba. El liderazgo no es intimidación, a diferencia de lo que parece pensar la actual administración estadounidense. Por Andrew Korybko. Este mes marca el 60 aniversario de la Crisis de los Misiles en Cuba, que fue lo más cerca que el mundo estuvo jamás de una guerra nuclear. Estados Unidos y la Unión Soviética se enfrentaron por Cuba, donde este último había desplegado en secreto armas nucleares en respuesta a que Washington las había desplegado anteriormente en Turquía


LeerMás



La Tierra no tiene sólo dos movimientos, en realidad tienen cinco y hay quienesseatrevena decir que tiene muchísimos más pero que no hemos sido capaces de contabilizarlos todavía. Por: Ecoo Sfera. A menudo pensamos que el tiempo es una medida absoluta e inmutable que nos contabiliza el pasar de los días sin variación alguna. Pero solemos olvidar que de hecho el tiempo está dado por lo que Einstein describió de manera magistral en su Teoría de la Relatividad General. Son los movimientos derivados de los campos gravitacionales de los astros, los que determinan el pasar de los segundos y lamentablemente, los movimientos de la Tierra no son nada sencillos, tan es así que en la escuela se nos suele explicar sólo por encima lo que realmente sucede


LeerMás


Nada de esto sería totalmenteposiblesinun profesional y eficiente trabajo mediático que en pocos años ha logrado generar un mundo paralelo, envenenando gravemente la conciencia de millones de personas. Se construyó el holograma de un país independiente, donde lo único real es la sangre de sus habitantes convertidos en rehenes de la locura nacionalista y carne de cañón del imperio. Oleg Yasinsky. En las redes sociales en ruso se han viralizado estas dos imágenes: una, la de transeúntes en Kreschatik, la calle central de Kiev, posando con el fondo del puente de Crimea en llamas producto de un ataque terrorista ucraniano; y otra, la de cadáveres de civiles



Como toda inflación, la actual crisis de precios es en el fondo un conflicto entre clases sociales por la distribución de una oferta limitada de bienes que la sociedad en su conjunto puede producir. CHRISTOPHER OLK. Los costes de la calefacción, la vivienda, la alimentación y la movilidad se disparan, la crisis social llega a su punto álgido. Cada vez son más las personas que se dan cuenta de que ya no pueden permitirse cubrir las necesidades más básicas de la vida cotidiana. Ya que el gobierno federal se enfrenta, en el mejor de los casos, a la dramática subida del coste de la vida pero se niega a tomar medidas eficaces, es inminente un "otoño caliente" de protestas sociales... Leer Más

ESTARÍAN VAGANDO POR LA VÍA LÁCTEA Miles de millones de supertierras habitables estarían vagando por la Vía Láctea.
Tendrían mejores condiciones que nuestro planeta para albergar vida, aunque habitabilidad no significa que estarían habitadas. Chris ImpeyTucson, Arizona. Los astrónomos han constatado que planetas como la Tierra no son los más indicados para la vida y que los verdaderamente prometedores son supertierras más grandes que nuestro planeta, con mejores atmósferas y océanos. Podría haber miles de millones de ellas vagando por la Vía Láctea. Chris Impey

Leer Más

Musk presentó Optimus: un nuevo robot humanoide que podría cambiarlo todo. El proyecto de la empresa Tesla está en una fase

po-
cómo





La frase es de Juarez Guimarães, profesor de Ciencias Políticas de la Universidad Federal de Minas Gerais: “La cuestión decisiva sigue siendo la de formar una mayoría popular”. POR GILBERTO LOPES. Conocidos los resultados de la primera vuelta electoral en Brasil, podríamos decir –siguiendo la sugerencia del profesor Guimarães– que la cuestión decisiva es cómo formar esa mayoría popular, necesaria para cambiar el rumbo de Brasil. En Brasil este es un tema urgente, que tiene fecha: 30 de octubre de 2022. Se trata de consolidar un frente capaz de derrotar

Leer Más

La señal del cambio del campo magnéticoesdébilpero estadísticamente significativa. Pablo Javier Piacente. Los magnetómetros han detectado señales débiles de modificaciones en el campo magnético antes de distintos terremotos ocurridos en las fallas de California entre 2005 y 2019: podrían mejorar nuestra comprensión de lo que sucede antes de los terremotos y ofrecer una promesa para la detección temprana. Un grupo de científicos de las firmas privadas Stellar Solutions y Google Accelerated Science, en Estados Unidos, concluyeron en un nuevo estudio publicado recientemente en la revista Journal of Geophysical Research: Solid Earth que existen débiles señales en el campo magnético de la Tierra que se registran con antelación a los terremotos

LeerMás

Un cambio de gabinete no es algo extraño en el desempeño de un gobierno; sin embargo, en este caso sí lo ha sido: marca un antes y un después en la corta vida de aquello que iba a ser el Gobierno del pacto Apruebo /Dignidad. Por Manuel Acuña Asenjo. Una de las primeras consecuencias del aplastante triunfo del Rechazo, en el reciente plebiscito, fue el cambio de gabinete del gobierno de la coalición Apruebo Dignidad, hecho ocurrido en los días 05 y 06 del mismo mes, hecho que se veía venir desde hacía bastante tiempo; especialmente, luego de las fallidas intervenciones de la ministra del Interior Izkia Siches y los poco felices encuentros entre el ministro Secretario General de Gobierno Giorgio Jackson con los sectores de la ex Concertación

LeerMás







ONU: Las olas de calor extremas harán inhabitables varias regiones en unas décadas. La organización señala que las olas de calor podrían alcanzar y superar los límites fisiológicos y sociales del ser humano en regiones como elSahel, el Cuerno de África y parte de Asia. Las olas de calor serán tan extremas en algunas regiones del mundo dentro de unas décadas que la vida humana será insostenible en esas zonas, según se desprende de un informe difundido este lunes por la Oficina de Naciones Unidas para la Coordinación de Asuntos Humanitarios y la Federación Internacional de Sociedades de la Cruz Roja y de la Media Luna Roja

Leer Más

“Se trata de un descubrimiento muy emocionante y esperamos completar la excavación en las dos próximas expediciones de campo. Basándonos en el pequeño tamaño de la cola y el pie, es probable que se trate de un espécimen joven”. Un hadrosario que conserva su piel. Por: Ecoo Sfera. Encuentran en Canadá, los restos fósiles de un dinosaurio pico de pato que se destaca de todos los demás hallazgos, por conservar su piel. Un raro descubrimiento que promete dar mayor luz sobre el desarrollo de los hadrosaurios. Cuando se trata de descubrimientos fósiles, normalmente se trata de restos óseos o incluso de impresiones en el sedimento terrestre

Leer Más


SE

DE
NUEVAS
DELCOSTO
El creciente populismo exacerbado por la crisis energética que arrastra al continente a una lucha a largo plazo. Por los reporteros del GT. Una gasolinera en el centro de París está fuera de servicio por escasez de combustible el 10 de octubre de 2022. Una huelga en Total Energies y ExxonMobil ha provocado escasez de combustible en muchas estaciones de servicio en Francia durante diez días. Foto: VCGNuevas oleadas de protestas contra el aumento del costo de vida en medio de una creciente crisis energética han golpeado a Europa en los últimos días, ya que muchas personas estaban enojadas porque sus gobiernos estaban librando una guerra contra su propia gente
LeerMás

Estados Unidos disfruta viendo la escalada de la guerra. 1. El conflicto en sí parece haber pasado de ser un polvorín a convertirse en un reactor nuclear, debido a ciertas fuerzas que han estado avivando las llamas de la guerra. Entre ellos estaba la retórica radical del presidente estadounidense Joe Biden sobre la llamada amenaza de Armagedón. Por tiempos globales. Esta captura de video tomada y publicada el 8 de octubre de 2022 muestra un espeso humo negro saliendo de un incendio en el puente de Crimea que conecta la península de Crimea con Rusia continental. Foto: AFP. Los últimos días han estado llenos de conmociones en el conflicto Rusia-Ucrania

Leer Más


Las únicas naves humanas que han atravesado la heliopausa hasta ahora han sido las legendarias Voyager 1 y 2, desde donde los investigadores han obtenido datos preciados para comprender esta región de nuestro sistema. Por: Ecoo Sfera. Al igual que la Tierra que está recubierta por su poderoso campo magnético, el Sistema Solar también tiene su propio escudo protector que lo divide como una célula del espacio intergaláctico. El límite entre nuestro vecindario y la extrañeza del espacio, no está muy clara del todo para los astrofísicos pero creen que algo extraño está sucediendo ahí y está ondulando de manera aberrante

LeerMás



El viejo concepto de plusvalía palidece ante la capacidad reproductiva de los grandes capitales. Y así es que la OIT advierte de que el acceso al empleo no es garantía de evitación de la pobreza. Por Sergio Pérez González. Emmanuel Macron anunció hace unas semanas el fin de la abundancia. En concreto, el presidente de la República Francesa dijo: “Vivimos el fin de lo que podía parecer una triple abundancia: la de la liquidez sin coste (…), la de productos y tecnologías (…) y de tierras, materias primas y agua”… Leer Más



modelo neoliberal está en crisis, y al sentirse amenazado pone en marcha todas las herramientas a su alcance para evitar un posible cambio. Esto explica la oleada de estrategias de ultraderecha que utiliza la desinformación como mecanismo de inestabilidad política y está obteniendo éxitos electorales en países del norte global. Ana María Aragonés. Los flujos migratorios que hemos considerado como forzados, es decir, personas que se movilizan por necesidad, de acuerdo con la Organización de Naciones Unidas (ONU), alcanzaron 79.5 millones de personas en 2019... Leer Más
Esos vacíos de poder han llegado a extremo tal, que
hoy, en vez de tener primeras planas sobre nuevos compromisos globales de cara a la emergencia climática, hablan de un potencialArmagedón si el Kremlin y el mundo siguenenrutadecolisión. No lo acabamos de entender, pero de 2030 a 2050 la vida en el planeta cambiará drástica y aceleradamente, dada la incapacidad de nuestra especie para frenar la vorágine destructiva. David Penchyna Grub. Afines del siglo XX, cargando con el siglo más devastador para el planeta en términos medioambientales y climáticos, con independencia de la tragedia del covid19 y la guerra en Ucrania, la responsabilidad de los gobiernos y las


LeerMás


Científicos resuelven un misterio químico de más de 200 años. Estos hallazgos podrían ayudar a comprender mejores procesos químicos de vital importancia, como la fotosíntesis o la respiración celular. La forma en la que los protones se mueven a través del agua era un fenómeno que no había logrado ser explicado de forma satisfactoria durante 200 años, desde que Theodor Grotthuss propuso una teoría al respecto. Sin embargo, los resultados de una reciente investigación conducida por un equipo internacional de académicos han conseguido demostrar una teoría que da respuesta a esa incógnita, informa la Universidad Ben-Gurion

Se descubrió que el agua del océano subterráneo en Encélado es "similar al agua de soda quelagentebebeenlaTierra", comunicaron los científicos. El fósforo en forma de ortofosfato (p. ej., HPO4-2) es probablemente abundante en el océano subterráneo de la luna Encelado de Saturno. Un equipo internacional de científicos halló evidencias de la existencia de abundantes cantidades de fósforo, un componente clave para la vida, disueltas en el océano subterráneo de Encélado, la luna de Saturno. La nave espacial Cassini descubrió el agua líquida del subsuelo de Encélado y analizó muestras a medida que columnas de granos de hielo y vapor de agua brotaban al espacio desde las grietas en la superficie helada de la luna, según comunicaron recientemente

LeerMás


Ambos, Putin y Biden –y aliados de ambos– comparten responsabilidad por lo que debería de ser un delito de lesa humanidad: amenazar a la humanidad proclamando que están dispuestos a contemplar el apocalipsis en sus juegos de poder con todo y sus justificaciones racionales. Mad (Locura) la doctrina del llamado equilibrio nuclear,... Esa doctrina se llamaba Destrucción Mutua Asegurada y sus siglas en inglés son MAD, palabra que se traduce como loco. Sigue vigente... y sigue siendo una locura. David Brooks. Joe Biden advirtió el jueves pasado que estamos al borde del Armagedon, si es que su contrincante Vladimir Putin cumple con su amenaza de usar un arma nuclear táctica en Ucrania. Tanto Biden como Putin han amenazado con consecuencias

LeerMás



La promesa de la transición verde no implica más que una sustitución de magnitudes, pasarían de las viejas industrias contaminantes a las nuevas verdes. El capitalismo ha llegado a su madurez y parece gripado de éxito. Este es un factor rara vez tenido en cuenta, pero en el que radica seguramente el centro de la crisis arrastrada desde 1973 y que estalla con nuevas formas en 2008. Emmanuel Rodríguez. El 1%. LA BOCA DEL LOGO. La lengua han dispone de un ideograma para nombrar algo aproximado a nuestro concepto de crisis: 危机. En chino mandarín se pronuncia wēijī. Como ocurre en tantos otros casos, el término es lo suficientemente polisémico como para designar una situación de crisis, de peligro, de incertidumbre y también de posibilidad...LeerMás


DOSSIER: 1. Suman 139 líderes sociales asesinados durante el año en Colombia. La Defensoría del Pueblo de Colombia reportó que el activismo social es una de las actividades más impactadas por la violencia. Europa Press. Madrid. El Instituto de Estudios para el Desarrollo y la Paz (Indepaz) denunció el asesinato de dos líderes sociales en Colombia, con lo que son ya 139 los dirigentes sociales fallecidos en lo que va de año. El primer fallecido es Nancer Barrera Herrera, quien ejercía como presidente de la Junta de Acción Comunal (JAC) en la vereda Cerro Negro, municipio de Baraya, departamento de Huila. Individuos armados no identificados tirotearon a Barrera
Leer Más




Todos somos puntitos viviendo en un momento muy breve. Ninguno de nosotros estaba aquí hace un millón de años. Ninguno estará aquí en un millón de años. Y al universo no le importa. Simplemente sigue y sigue. El cosmos no tiene propósito; sólo nosotros lo tenemos. Cada cosa que puede existir, existirá un número infinito de veces. Esto significa que hay copias de nosotros en otras partes del universo. Fabrizio Mejía Madrid. Aquí camina el universo en todas direcciones: un fuelle hecho de vacío soplando cenizas que reviven. Esta frase del siglo sexto antes de nuestra era, atribuida al filósofo chino Lao-Tsé, encierra una de nuestras más antiguas certezas: el cosmos no tiene propósito; sólo nosotros lo tenemos

LeerMás




Hay quien dice que hablar de paz en tiempos de guerra es un signo de debilidad;peroeslocontrario. Exigimos la ilegalización de las armas atómicas como instrumentos de intimidación y asesinato en masa de los pueblos. Exigimos un estricto control internacional para hacer cumplir esta medida. La paz no es sólo la ausencia de guerra; es la seguridad real. La seguridad de saber que podrás comer, que tus hijas e hijos tendrán educación y cuidados y que un servicio de salud estará ahí cuando lo necesites. Hoy, para millones de personas, esto no es una realidad. Por Vijay Prashad. Desde 1947, el Reloj del fin del mundo ha medido la probabilidad de una catástrofe de origen humano, concretamente para advertir al mundo de la posibilidad de un holocausto nuclear
LeerMás


DOSSIER: Para que la vida se iniciara era imprescindible el agua, pero al mismo tiempo se requería un espacio fuera del agua para producir las reacciones originarias. 1. La Vida Habría Comenzado. En El
Límite Entre El Agua Y El Aire. Las primeras reacciones químicas que hicieron posible la vida en la Tierra se habrían originado a través de una súbita interacción entre el agua y el aire. Los científicos... reprodujeron estas condiciones naturales y comprobaron que en ese límite entre las gotas de agua y el aire se llevan a cabo de manera espontánea las reacciones que derivan en la formación de aminoácidos, péptidos y proteínas. En consecuencia, parece una explicación muy interesante para comprender cómo podrían haberse producido los enlaces químicos iniciales que inauguraron la magia de la vida en la Tierra primitiva

Leer Más


”
No somos conscientes de que además de vivir de la naturaleza también vivimos con ella, en ella e incluso como ella. El dominio de la visión cortoplacista sobre la naturaleza está respaldado, en gran medida, por el sistema neoliberal. Indicadores como el PIB más que ayudarnos a navegar hacia la sostenibilidad, aceleran el metabolismo social que erosiona la relación con la naturaleza. Gorka Castillo. Unai Pascual. G. C. Hace años que los seres humanos rebasaron los límites del mundo. El impacto de su actividad sobre la biodiversidad de la Tierra es realmente profundo. La rapidez del cambio climático, revelada en todos los informes periódicos del Grupo Intergubernamental de Expertos sobre el Cambio Climático

LeerMás


Las opciones para el pueblo haitiano pasarán por la unión de los sindicatos a la ola de protestas. Falta ver si éstos y las organizaciones comunitarias (incluidos los grupos de estudiantes que han resurgido como actores clave) serán capaces de impulsar un cambio. Vijay Prashad. En julio de 2018 empezó un ciclo de protestas en Haití que aún se mantiene. El principal motivo inicial fue que en marzo de ese año el gobierno de Venezuela (debido a las sanciones ilegales impuestas por Estados Unidos) no podía seguir enviando petróleo con descuento a la isla a través de Petrocaribe. Los precios de los combustibles se dispararon hasta en 50 por ciento

LeerMás

La repetición de formas y estructuras espaciales nos induce a creer que estamos reviviendo unaexperiencia. Pablo Javier Piacente. Una inves-
tigación ha comprobado que el popular fenómeno conocido como “déjà vu”, que aparece cuando tenemos la sensación de que estamos reviviendo una experiencia, se debe a que la repetición de formas y estructuras espaciales nos hace creer que una situación que estamos viviendo ya fue experimentada con anterioridad. El popular fenómeno conocido como déjà vu, que ha propiciado numerosas teorías científicas y pseudo-científicas en el pasado, podría explicarse a través de un mecanismo denominado familiaridad Gestalt
LeerMás



Ya se conocía que esta estructura cerebral está vinculada al condicionamiento del miedo, pero su relación con la memoria de emociones aún no era clara. Un grupo de investigadores de la Universidad de Basilea (Suiza) reveló que el cerebelo, una estructura cerebral encargada principalmente de controlar las funciones motoras del cuerpo humano, también tiene la capacidad de procesar los recuerdos emocionales. De acuerdo con los autores del estudio, publicado en la revista PNAS, evidencias científicas anteriores indicaban que la amígdala (situada en el lóbulo temporal del cerebro), así como sus interacciones con otras regiones cerebrales, desempeñan un papel central en el almacenamiento de las experiencias emotivas

LeerMás

DOSSIER: “Petro ganó con una bandera, que era cumplir el acuerdo de paz y eso es hacer la democracia.” El gobierno compró las tierras a la federación ganadera para cumplir el acuerdo con las Farc. 1. Colombia: tres millones de hectáreas fértiles para los campesinos. Mientras, avanza en el Congreso la reforma tributaria y el gobierno le entrega la titularidad de casi 300,000 hectáreas a comunidades indígenas. El gobierno de Petro compro tierras a los ganaderos para repartirlas entre los campesinos. Imagen: EFE. El Gobierno de Colombia logró un acuerdo con la organización ganadera más importante del país para comprarle las tres millones de hectáreas con las que el Ejecutivo aspira a avanzar en el cumplimiento del acuerdo de paz con las FARC y encarrilar su proyecto de reforma agraria. Acuerdo con ganaderos

Leer Más

Gürol Süel, profesor de la Universidad de California en San Diego, EE.UU., indicó que esta investigación les hizo cambiar la percepción que tenían sobre las esporas, a las que consideraban "objetos inertes". Süel Lab / Kaito Kikuchi / Leticia Galera. Un grupo de investigadores de instituciones científicas de Estados Unidos y España descubrió que las esporas bacterianas tienen la capacidad de analizar su entorno, a pesar de encontrarse fisiológicamente muertas, informó este jueves la Universidad de California, en San Diego, EE.UU. De acuerdo con los responsables del estudio, publicado en la revista Science, las esporas, que son células parcialmente deshidratadas
LeerMás




























ANIMANDO
EN COLOMBIA
MENTIRAS PELIGROSAS
SOREL Y LA MORAL
Y POBREZA
DE ESTRELLAS DE NEUTRONES
VELOCIDAD DE LA LUZ
PROPONEN ESCUDO MAGNÉTICO EN MARTE PARA QUE SEA HABITABLE
LA TRAMPA DE ESCAZÚ
HUMANOS MODERNOS Y NEANDERTALES COEXISTIERON EN FRANCIA Y NORTE DE ESPAÑA ENTRE 1.400 Y 2.900 AÑOS
"HAY RIESGO DE RECESIÓN GLOBAL"
IMPLANTAN CÉLULAS HUMANAS EN RATONES Y LOGRAN INFLUIR EN SU COMPORTAMIENTO
EUROPA SUBTERRÁNEA: NO A LA GUERRA
NOBEL DE ECONOMÍA 2022 RESPONSABLE DE SALVAR BANCOS EN LA CRISIS DE 2008
EL IMPERIO POR UNAS ELECCIONES
OCCIDENTE INFLAMA LA GUERRA NUCLEAR, Y SU INESTABLE MARIONETA ZELENSKY PUEDE DESTRUIR EL PLANETA
BEBÉ RECIBE PRIMER TRASPLANTE DE INTESTINO CON TÉCNICA INNOVADORA
TARDE O TEMPRANO, EE. UU. PAGARÁ EL PRECIO DE SU ARRO-GANCIA Y EGOÍSMO AUTORITARIOS
‘BOTA’ EXOESQUELÉTICA, NUEVO PASO HACIA LOS FUTUROS DISPOSITIVOS DE MARCHA ASISTIDA
NEURONAS HUMANAS CULTIVADAS PUEDEN APRENDER MEDIANTE SEÑALES ELÉCTRICAS
OTAN SIGUE ESFORZÁNDOSE DESCARADAMENTE POR CONVERTIR CONFLICTO RUSIA UCRANIA DE VIDA O MUERTE
DESARROLLAN UNA BATERÍA QUE PERMITE CARGAR UN VEHÍCU-LO ELÉCTRICO EN TAN SOLO 10 MINUTOS
EE. UU. DEBE DEJAR DE CREER QUE ESTÁ POR ENCIMA DE LOSDEMÁS
ENCUENTRAN UN SEXTO OCÉANO ESCONDIDO EN LAS ENTRAÑAS DE LA TIERRA
LA DESHUMANIZACIÓN: UCRANIA COMO LABORATORIO
LA ROTACIÓN DE LA TIERRA ESTÁ CAMBIANDO Y AFECTANDO EL TIEMPO
NO HAY ESTABILIDAD DE PRECIOS EN UN PLANETA MORIBUNDO SUPERTIERRAS HABITABLES ESTARÍAN VAGANDO POR LA VÍA LÁCTEA
BANCO MUNDIAL, GEOPOLÍTICA Y MALDESARROLLO
¿SE VIENE LA REVOLUCIÓN DE LAS MÁQUINAS?

LECCIONES EN BRASIL Y LA LUCHA DE LA IZQUIERDA: LA CUES-TIÓN DECISIVA SIGUE SIENDO LA DE FORMAR UNA MAYORÍA POPULAR
LIGEROS CAMBIOS EN CAMPO MAGNÉTICO PRECEDEN A TERREMOTOS
OBITUARIO PARA UN GOBIERNO QUE NO PUDO SER
LA URGENCIA DE PARAR LA GUERRA
OLAS DE CALOR EXTREMAS HARÁN INHABITABLES VARIAS REGIONES DEL PLANETA
EL CONGRESO DE COLOMBIA RATIFICA EL ACUERDO DE ESCAZÚ TRES AÑOS DESPUÉS DE SU FIRMA
EUROPA SUMIDA EN UNA CRISIS MÁS PROFUNDA A MEDIDA QUE SE DESARROLLAN NUEVAS OLEADAS DE PROTESTAS POR EL AUMENTO DEL COSTO DE LA ENERGÍA Y LA INFLACIÓN DESCUBREN FÓSIL DE DINOSAURIO QUE AÚN CONSERVA LA PIEL
EL CONFLICTO ENTRE RUSIA Y UCRANIA SE INTENSIFICA DEBIDO A LAS LLAMAS AVIVADAS POR EE. UU.
EL SISTEMA SOLAR PARECE ESTAR ONDULANDO Y NADIE SABE POR QUÉ
EL SUEÑO DE LA ABUNDANCIA PRODUCE MONSTRUOS
CRISIS DEL NEOLIBERALISMO Y LA ULTRADERECHA ¿CÓMO SE MUEVEN LOS PROTONES EN EL AGUA?
DOS MUNDOS INCONEXOS
DESCUBREN UN COMPONENTE CLAVE PARA LA VIDA EN UNA LUNA DE SATURNO LOCURA
CREAN NUEVAS PROTEÍNAS QUE IMITAN A LAS INMUNOGLOBULINAS DE LOS ANTICUERPOS SIGUEN ASESINATOS DE LÍDERES SOCIALES EN COLOMBIA
LA SITUACIÓN MÁS PELIGROSA QUE HA ENFRENTADO LA HUMANIDAD
LAS GOTAS DE AGUA, CLAVE QUÍMICA DEL ORIGEN DE LA VIDA POR QUÉ LA CRISIS NO TIENE SOLUCIÓN
LA LECCIÓN DEL INFINITO CONTRA LA RIQUEZA EXTREMA
“
EL PIB COMO INDICADOR REY DEL PROGRESO ES UNA DE LAS MAYORES FALACIAS DE NUESTRA SOCIEDAD”
EL FENÓMENO DEL DÉJÀ VU SE DEBE A UNA CONFUSIÓN DE NUESTRA MEMORIA
HAITÍ: CUATRO AÑOS DE PROTESTAS ININTERRUMPIDAS DESCUBREN QUE EL CEREBELO PUEDE ALMACENAR LAS EXPERIENCIAS EMOCIONALES
GOBIERNO PETRO COMPRÓ TRES MILLONES DE HECTÁREAS FÉRTILES PARA CAMPESINOS
DESCUBREN QUE BACTERIAS "MUERTAS" PUEDEN VOLVER A LA VIDA